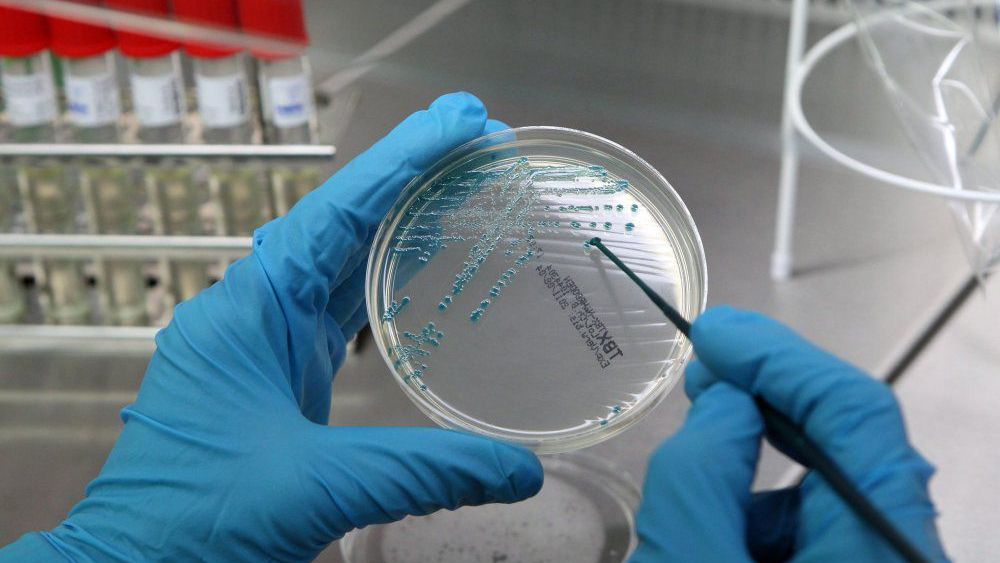
zdjęcie

E.coli może mieć związek z rakiem jelita grubego
Zakażenie wytwarzającym specyficzną toksynę szczepem pospolitej bakterii jelitowej E.coli może zwiększać ryzyko raka jelita grubego. Co więcej, szczep ten sprzedawany jest niekiedy jako probiotyk – informuje „Nature”.
Raka jelita grubego co roku diagnozuje się u 18 tys. Polaków, zaś umiera z jego powodu aż 12 tys. osób. Około połowie przypadków można by zapobiec dzięki odpowiedniej diecie, rezygnacji z alkoholu, rzuceniu palenia i zachowaniu właściwej wagi ciała. Typowe objawy to trwała zmiana typowego rytmu wypróżnień, krew w kale, utrzymujący się ból brzucha oraz częste wzdęcia. W większości przypadków takie objawy są spowodowane przez coś innego, jednak jeśli jeden lub więcej z nich trwa ponad 4 tygodnie, warto odwiedzić lekarza rodzinnego.
Escherichia coli, zwana też pałeczką okrężnicy, to beztlenowa bakteria która – jak sama nazwa wskazuje – zamieszkuje nasze jelita. Dlatego zresztą jej obecność w wodzie wskazuje na zanieczyszczenie fekaliami.
W normalnych warunkach E. coli spełnia pożyteczną rolę, pomagając w trawieniu pokarmów oraz wchłanianiu składników pokarmowych. Jednak niektóre jej szczepy mogą wytwarzać toksyny i powodować zachorowania – na przykład „biegunkę podróżników” czy zatrucia pokarmowe prowadzące do uszkodzenia nerek.
Nowe badania międzynarodowego zespołu z holenderskiego uniwersytetu Hubrecht, Princess Maxima Center w Utrechcie oraz uniwersytetów w Leeds i Bostonie wykazały, że kolibaktyna – toksyna wytwarzana przez specyficzny szczep E. coli występujący u co piątej osoby – może powodować mutacje w komórkach wyściełających jelito, co z czasem potencjalnie mogłoby spowodować zmiany nowotworowe. Kolibaktynę wytwarza również inna bakteria często obecna w jelicie i drogach oddechowych – Klebsiella pneumoniae.
Naukowcy hodowali małe fragmenty ludzkiego jelita, będące modelami tego narządu (organoidy) i wstrzykiwali do nich wytwarzające kolibaktynę bakterie E. coli w dni powszednie przez pięć miesięcy. Pod koniec każdego tygodnia bakterie usuwano za pomocą antybiotyku – inaczej robiło się ich zbyt dużo i rozrywały miniaturowe jelito.
Po pięciu miesiącach naukowcy porównali DNA z jelit, do których wprowadzano E.coli, wytwarzające kolibaktynę – oraz jelit kontrolnych, w których był szczep genetycznie niezdolny do wytwarzania tej toksyny. Dokładne badanie ujawniło, że kolibaktyna uszkadza DNA w charakterystyczny sposób, działając na poszczególne elementy DNA. Dochodziło na przykład do uszkodzeń kluczowego genu przeciwnowotworowego APC. Komórki próbowały naprawiać uszkodzenia, co jednak często prowadziło do błędów sprzyjających powstawaniu nowotworu.
Następny krokiem była analiza ponad 5000 próbek DNA pobranych od pacjentów z różnymi nowotworami. Typowe dla kolibaktyny uszkodzenia materiału genetycznego były obecne w ponad 5 proc. przypadków raka jelita grubego, ale w mniej niż 0,1 proc. innych. Wśród tych innych były nowotwory jamy ustnej i pęcherza, które E. coli także może zakazić.
Jak zauważył dr Hans Clevers z uniwersytetu Hubrecht, jeden z wytwarzających kolibaktynę szczepów E.coli sprzedawany jest jako probiotyk, mający pomagać na zaparcia, biegunkę dziecięcą i zespół jelita drażliwego (ale nie chodzi tu o bakterie obecne w jogurtach). Zdaniem naukowca choć taka suplementacja może przynieść krótkookresową ulgę, w dalszej perspektywie prawdopodobnie sprzyja rakowi.
Jak dotąd nie ma rutynowych testów, które wykrywałyby obecność wytwarzających kolibaktynę bakterii. Nie jest też jasne, czy i w jakim stopniu osoby, w których jelicie jest obecna będą narażone na podwyższone ryzyko raka. Potrzebne są dalsze prace.
Jeśli jednak związek pomiędzy zakażeniem a zachorowaniem zostanie potwierdzony, dzięki badaniom przesiewowym i eliminacji fatalnego szczepu można będzie zapobiec tysiącom zachorowań albo przynajmniej je opóźnić. W grę wchodzi kuracja antybiotykowa oraz przeszczep kałowy, czyli zasiedlenie jelita „zdrowymi” bakteriami. Ponadto testy wykrywające kolibaktynę mogłyby pomóc we wcześniejszym rozpoznawaniu raka jelita grubego.
Wcześniejsze badania wykazały związek pomiędzy zakażeniem wirusem HPV a rakiem szyjki macicy w przypadku oraz rakiem żołądka i obecnością w nim bakterii Helicobacter pylori. Prawdopodobnie więc rola E. coli nie jest ostatnim odkryciem w tej dziedzinie.(PAP)